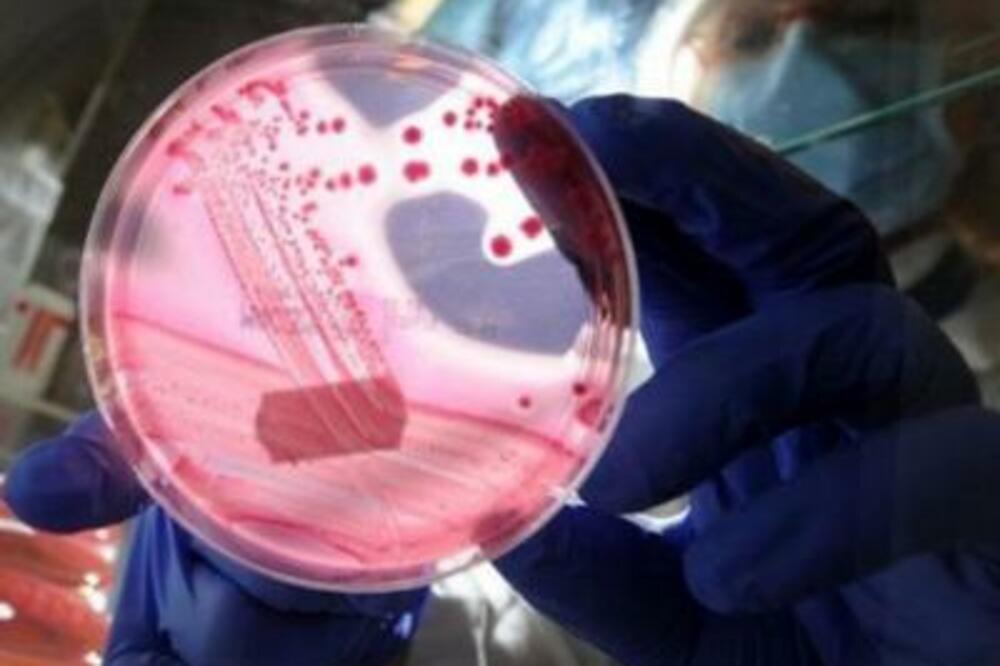
Ešerihija koli, Foto: Smedia.rs

Francuske medicinske službe istražuju dva nova sumnjiva slučaja ešerihije koli povezana sa konzumiranjem hamburgera od kojih je već oboljelo sedmoro djece, rekaoje francuski ministar zdravlja Gzavije Bertran.Francuske vlasti su naložile povlačenje 10 tona zamrznutih goveđih hamburgera proizvedenih u Francuskoj a koje se prodaju u njemačkom lancu samoposluga Lidl.
Oni međutim navode da ovaj slučaj nije povezan sa smrtonosnim sojem bakterije ešerihije koli koji se pojavio u Njemačkoj.Sedmoro djece staro između 18 mjeseci i osam godina nalaze se na bolničkom liječenju zbog ešerihije koli kojom su se, kako se vjeruje, zarazili od hamburgera kupljenih u sjevernoj Francuskoj.Francuski ministar je rekao da se još dva pacijenta ispituju na ešerihiju koli i da se rezultati očekuju ove nedjelje.
Regionalni zvaničnik za zdravstvo rekao je da je to dvoje djece jelo iste hamburgere i da su kasnije imali jaku dijareju.Ljekari sa Univerzitetske bolnice u Lilu u sjevernoj Francuskoj rekli su na konferenciji za štampu da je jednom od hospitalizovane djece, starom dvije godine, potrebna pomoć za disanje i da ga drže u vještački izazvanoj komi.To dijete je pojelo jedno od goveđih hamburgera koji je bio samo malo pečen i ministar zdravlja je pozvao roditelje da dobro ispeku meso.Proizvođač hamburgera, francuska kompanija SEB, saopštila je da je meso za hamburgere došlo sa farmi u Francuskoj, Njemačkoj i Holandiji i da su hamburgeri analizirani prije nego što su isporučeni supermarketima.
Lidl je saopštio da je sklonio sve ove hamburgere iz svojih radnji.Francuski zdravstveni zvaničnici su rekli da se ovaj soj esšerihje koli dosta redovno pojavljuje u Francuskoj.U Evropi je zbog trovanja bakterijom enterohemoragične ešerihije koli (EHEC) do sada umrlo 38 ljudi - 37 u Njemačkoj i jedna žena u Švedskoj, koja je prethodno boravila u Njemačkoj.
Ustanovljeno da je infekcija izazvana klicama pasulja sa gazdinstva u sjevernoj Njemačkoj.Njemački zdravstveni zvaničnici su rekli da se smanjuje broj oboljelih ali još nijesu ustanovili kako su klice zaražene.
Pogledajte još:
Preuzmi aplikaciju i prati vijesti
PRATITE NAS NA